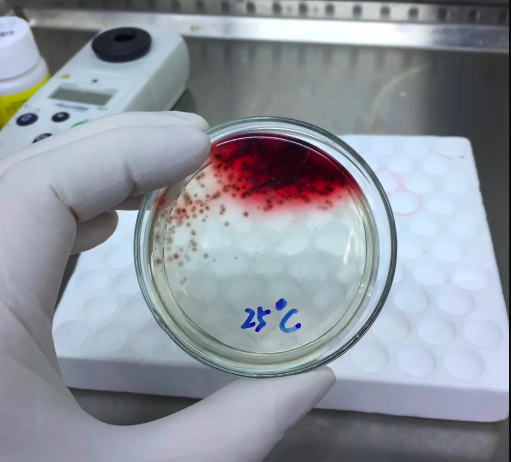

benshenmed(官方) 2020年04月14日
形态学 770
马尔尼菲青霉菌
血液培养出来的马尔尼菲,免疫缺陷病人(AIDS等)易感染,25度红色色素


亚甲蓝染色
马尔尼菲青霉菌
属于半知菌、丝孢菌纲、丝孢目、丛梗孢科、青酶属。
其特征是双向性,在自然界中以菌丝形式存在,在组织中则可形成小圆形到椭圆形细胞。
全屏 最小
benshenmed(官方) 2020年04月14日
形态学 770
马尔尼菲青霉菌
血液培养出来的马尔尼菲,免疫缺陷病人(AIDS等)易感染,25度红色色素

亚甲蓝染色
马尔尼菲青霉菌
属于半知菌、丝孢菌纲、丝孢目、丛梗孢科、青酶属。
其特征是双向性,在自然界中以菌丝形式存在,在组织中则可形成小圆形到椭圆形细胞。
全屏 最小
检验速记关闭
APP下载